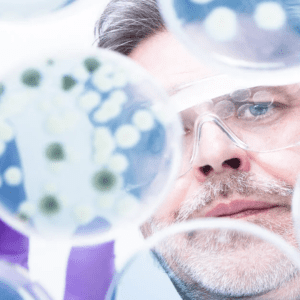
1 1 300x300

Unlock the Benefits of Biohygiene: Cleaner, Safer, and More Sustainable Cleaning Solutions for Your Business
In today’s fast-paced world, businesses require cleaning solutions that are not only efficient but also sustainable. This is where Biohygiene products shine—offering an innovative approach to cleaning that is safer, quicker, and more eco-friendly. By leveraging the power of biotechnology, these products deliver superior cleaning performance while minimising environmental impact. At IG Cleaning and
In today’s fast-paced world, businesses require cleaning solutions that are not only efficient but also sustainable. This is where Biohygiene products shine—offering an innovative approach to cleaning that is safer, quicker, and more eco-friendly. By leveraging the power of biotechnology, these products deliver superior cleaning performance while minimising environmental impact.
At IG Cleaning and Hygiene Supplies, we’re excited to introduce you to the next generation of cleaning: biotech-powered cleaning products. Here’s why you should consider making the switch today.
At IG Cleaning and Hygiene Supplies, we’re excited to introduce you to the next generation of cleaning: biotech-powered cleaning products. Here’s why you should consider making the switch today.
What Makes Biohygiene Products Different?
Unlike traditional cleaning agents, Biohygiene products combine advanced biotechnology and ecotechnology to provide a deep, long-lasting clean. These products are super concentrated, meaning they pack more cleaning power into smaller amounts, which offers benefits like lower costs, easier storage, and reduced environmental footprint.
Our Biohygiene solutions focus on creating a residual cleaning action, which works even after you’ve finished scrubbing. This means that over time, surfaces stay cleaner longer, reducing the frequency of cleaning and making it easier to maintain a hygienic environment.
Why Switch to Biohygiene Products?
 Here are some key reasons why Biohygiene products are the best choice for modern businesses:
Here are some key reasons why Biohygiene products are the best choice for modern businesses:
-
Super Concentrated for Cost Efficiency
With high dilution rates, Biohygiene products allow businesses to reduce the number of cleaning products they need. This not only minimises the need for storage but also translates into significant cost savings. One bottle of super concentrate can tackle multiple cleaning tasks, reducing your overall spending on cleaning supplies.
-
Broad Spectrum Cleaning Power
Biohygiene products are versatile enough to handle 80% of cleaning requirements. From tackling fats, oils, and proteins to removing stubborn stains, these products are designed to offer broad-spectrum cleaning across different industries, including healthcare, hospitality, offices, and more. Whether you need to clean soft fabrics, grout, or tough surfaces, Biohygiene solutions make it easy and efficient.
-
Residual Cleaning Action
One of the standout features of Biohygiene products is their residual cleaning effect. After application, proprietary bacteria continue to work by forming biofilms on surfaces, where they break down organic matter like dirt, grease, and odour-causing substances. This creates a healthier, cleaner environment that requires less cleaning over time.
By removing organic residues and odours at the source, these products ensure a deeper, longer-lasting clean that saves time and effort in future cleaning sessions.
-
Minimal Hazard, Maximum Impact
Even in concentrated forms, Biohygiene products have minimal hazard classifications, making them safer for users and reducing risks in sensitive environments. This means less reliance on dangerous chemicals that could harm both human health and the environment. The technology behind these products ensures they are effective yet gentle on surfaces and the people using them.
 Biotechnology in Action: How it Works
Biotechnology in Action: How it Works
Biotechnology plays a crucial role in ensuring superior cleaning performance. Our Biohygiene products contain carefully selected strains of bacteria that produce specific enzymes to break down common forms of waste:
- Lipase: Breaks down fats, oils, and greases.
- Amylase: Tackles starches found in food residues like pasta and potatoes.
- Cellulase: Decomposes vegetable matter.
- Protease: Targets proteins from food, such as meats and cheeses.
- Uricase: Breaks down uric acid, which helps eliminate stains and odours in bathrooms.
These natural enzymes provide an extra layer of cleaning power that traditional chemical cleaners cannot match, offering a deeper and more comprehensive clean.
The Benefits of Going Biotech

Time and Cost Savings
Residual cleaning means fewer applications are needed, saving both time and labour. Cleaning operatives spend less time on repetitive tasks, allowing them to focus on other essential duties. Additionally, less product usage results in fewer purchases, cutting costs for your business.
Eco-Friendly Cleaning
Biohygiene products are kinder to the environment, requiring fewer applications, reducing waste, and minimising harmful chemical runoff. Using these solutions helps businesses lower their carbon footprint by reducing their reliance on harmful petrochemical-based products.
Improved Air and Water Quality
Traditional cleaners often contain harsh chemicals that can degrade air quality and damage aquatic ecosystems. Biohygiene products help reduce these risks, making them the sustainable choice for companies aiming to minimise their environmental impact.
Simplified Training and Usage
One of the hidden benefits of Biohygiene products is their ease of use. With a reduced number of products, training becomes simpler, and staff members can quickly learn how to use each product effectively. Fewer products also mean less confusion and more consistent cleaning results.
Let’s Get Started: A Greener, Cleaner Future
Switching to Biohygiene products is more than just a shift in how you clean—it’s an investment in the future of your business and the planet. By adopting these solutions, you’ll not only achieve superior cleaning results but also contribute to a more sustainable world.
Interested in seeing how Biohygiene products can transform your business? Contact us today at IG Cleaning and Hygiene Supplies to discuss your requirements and find the perfect solutions for your cleaning needs.
Cleaner, greener, and more efficient—discover the power of biotechnology today.
Our Latest News
View newsHow to Choose the Right Commercial Cleaning Chemicals for Your Business
Choosing the right cleaning chemicals for your business is about more than just picking products off the shelf. It also
View articleHow to Clean Care Homes Effectively: A Practical Guide for Managers and Staff
Maintaining a clean and hygienic care home is essential for resident safety, comfort and wellbeing. In a residential setting, cleaning
View articleAutumn Leaf Fall: Gutter, Drain & Exterior Cleaning for UK Businesses
As autumn arrives in the UK, falling leaves create more than just picturesque scenery, they can cause real problems for
View article